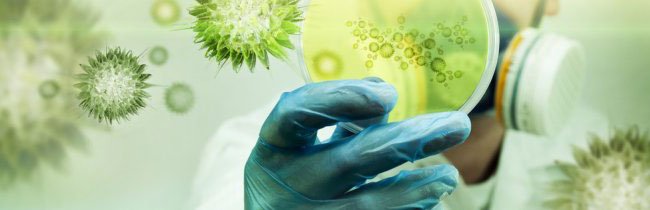

Obaveza u nastavi za studente prve godine u školskoj 2020/2021 godini.
Onlajn kurs "Prve pomoći" u školskoj 2020/2021 godini.
Onlajn kursevi obaveza u nastavi
Obaveza u nastavi za studente prve godine u školskoj 2020/2021 godini.
Onlajn kurs "Prve pomoći" u školskoj 2020/2021 godini.